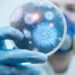
Cinsel yolla bulaşan virüs ülkede hızla yayılıyor

İstanbul Büyükşehir Belediye Başkanı Ekrem İmamoğlu Twitter adresinden yaptığı paylaşımda “Bu şehrin bütçesini buralara harcıyoruz. İstanbul’un her tarafında gece gündüz metro çalışmaları devam ediyor. Yeni metro araçlarımız da bir bir geliyor” dedi.